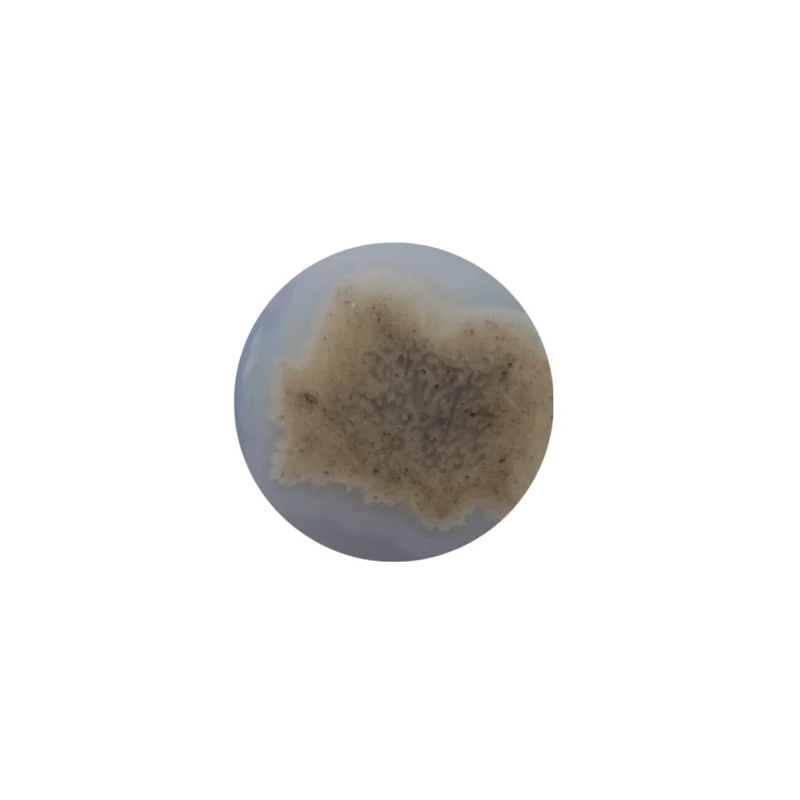
سنگ زینتی عقیق مدل گل دار Y2

سنگ زینتی عقیق مدل گل دار Y2
0%
(0 نفر) از خریداران، این کالا را پیشنهاد کرده اند
برند :
متفرقهویژگی ها
- جنس : عقیق
مشخصات محصول
این محصول یک نگین عقیق بسیار زیبا با رنگ آبی آسمانی با سایز درج شده در مشخصات کالا به همراه گل زیبای بهاری سفید در درون سنگ است.
این نگین زیبا در یک سمت دارای طرح بوده و میتواند به عنوان نگین انگشتری یا گردنبند مورد استفاده قرار گیرد. این نگین زیبا با طرح بی نظیر خود کاملا طبیعی و بدون بهسازی و دستکاری است.
این عقیق در همه جهات دارای پولیش عالی است.
با پوشیدن این عقیق زیبا جلوه ای خاص را تجربه خواهید کرد.
نوع سنگ زینتی
سنگ تراشخورده
جنس
عقیق
ابعاد
15.5x15.5x6.5 میلیمتر
وزن
3.8 گرم
















